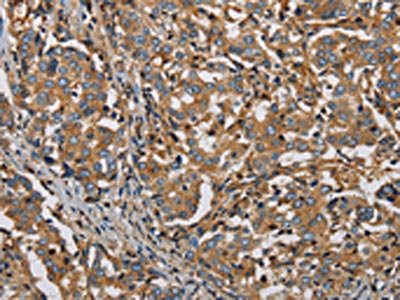

-
中文名稱:PLIN3兔多克隆抗體
-
貨號:CSB-PA954450
-
規格:¥1100
-
圖片:
-
The image on the left is immunohistochemistry of paraffin-embedded Human liver cancer tissue using CSB-PA954450(PLIN3 Antibody) at dilution 1/50, on the right is treated with synthetic peptide. (Original magnification: ×200)
-
The image on the left is immunohistochemistry of paraffin-embedded Human brain tissue using CSB-PA954450(PLIN3 Antibody) at dilution 1/50, on the right is treated with synthetic peptide. (Original magnification: ×200)
-
-
其他:
產品詳情
-
Uniprot No.:
-
基因名:PLIN3
-
別名:47 kDa mannose 6-phosphate receptor-binding protein antibody; 47 kDa MPR binding protein antibody; 47 kDa MPR-binding protein antibody; Cargo selection protein TIP47 antibody; M6PRBP 1 antibody; M6PRBP1 antibody; Mannose 6 phosphate receptor binding protein 1 antibody; Mannose-6-phosphate receptor-binding protein 1 antibody; MGC11117 antibody; MGC2012 antibody; MPR binding protein 47 kDa antibody; Perilipin 3 antibody; Perilipin-3 antibody; Perilipin3 antibody; Placental protein 17 antibody; PLIN3 antibody; PLIN3_HUMAN antibody; pp17 antibody; Tail interacting protein 47 kD antibody; TIP47 antibody
-
宿主:Rabbit
-
反應種屬:Human
-
免疫原:Synthetic peptide of Human PLIN3
-
免疫原種屬:Homo sapiens (Human)
-
標記方式:Non-conjugated
-
抗體亞型:IgG
-
純化方式:Antigen affinity purification
-
濃度:It differs from different batches. Please contact us to confirm it.
-
保存緩沖液:-20°C, pH7.4 PBS, 0.05% NaN3, 40% Glycerol
-
產品提供形式:Liquid
-
應用范圍:ELISA,IHC
-
推薦稀釋比:
Application Recommended Dilution ELISA 1:2000-1:5000 IHC 1:50-1:200 -
Protocols:
-
儲存條件:Upon receipt, store at -20°C or -80°C. Avoid repeated freeze.
-
貨期:Basically, we can dispatch the products out in 1-3 working days after receiving your orders. Delivery time maybe differs from different purchasing way or location, please kindly consult your local distributors for specific delivery time.
-
用途:For Research Use Only. Not for use in diagnostic or therapeutic procedures.
相關產品
靶點詳情
-
功能:Required for the transport of mannose 6-phosphate receptors (MPR) from endosomes to the trans-Golgi network.
-
基因功能參考文獻:
- High PLIN3 expression is associated with clear cell renal cell carcinoma. PMID: 29773494
- we found a DPP9-PPP6R3 fusion transcript in one tumor showing a matching genomic 11;19-translocation. Another tumor had a rearrangement of DPP9 with PLIN3. Both rearrangements were associated with diminished expression of the 3' end of DPP9 corresponding to the breakpoints identified by RNA-seq. PMID: 28893231
- Conserved amphipathic helices mediate lipid droplet targeting of PLIN1, PLIN2, and PLIN3. PMID: 26742848
- PLIN3 functions are intertwined with the lipogenic pathways implicated in sebaceous lipogenesis, such as desaturation and triglyceride synthesis. PMID: 25039349
- Postprandial triglyceride rich lipoproteins may be involved in atherosclerotic plaque formation through the regulation of perilipin-2 and perilipin-3 proteins in macrophages. PMID: 25595097
- Differential expression of PLIN3 and brefeldin A sensitivity may explain differential lipid oxidation efficiency in skeletal muscle among healthy lean, sedentary, and T2 diabetic males. PMID: 26171795
- Results indicate that microRNAs miR-148a and miR-30a, regulate Tail interacting protein of 47 kDa (TIP47) expression and lipid droplets (LD) in hepatitis C virus infected cells. PMID: 26170028
- Following exercise training, perilipin 3 protein expression was increased in the adipose tissue of women with polycystic ovary syndrome. PMID: 25342854
- Skeletal muscle perilipin 3 and coatomer proteins are increased following exercise and are associated with fat oxidation. PMID: 24632837
- Rab9-complexed TIP47 plays an essential role for the proper release of hepatitis C viral particles. PMID: 24480419
- PLIN3 is associated with the synthesis and secretion of PGE2 PMID: 23936516
- TIP47 plays an essential role in the life cycle of hepatitis C virus. PMID: 23354285
- studies identified the lipid droplet(LD-associated host protein, Tail-Interacting Protein 47 (TIP47) as a novel NS5A interaction partner; data support a model where TIP47-via its interaction with NS5A-serves as a novel cofactor for HCV infection possibly by integrating LD membranes into the membranous web PMID: 23593007
- TIP47 is here described for the first time as a viral restriction factor that acts by limiting viral protein synthesis. PMID: 23348195
- PLIN2-PLIN5 proteins were all more abundant in women than in men (p = 0.037 and p < 0.0001, respectively), consistent with higher intramyocellular lipid content in female skeletal muscle. PMID: 22667335
- Suppression of TIP47 in HeLa cells facilitated oxidative-stress-induced cell death. PMID: 20556887
- TIP47 is required for the encounter between Gag and Env, and thus for the generation of infectious HIV-1 particles from primary macrophages. PMID: 20070608
- can co-localize with lipid storage proteins PMID: 12077142
- Data show that placental protein 17b (PP17b)is a neutral lipid droplet-associated protein, and its expression is regulated by PKC- and PKA-dependent pathways PMID: 12631276
- TIP47 binding to HIV-1 envelope glycoprotein (ENV) is required for ENV transport to the trans-golgi network and for its incorportaion into virions and its pathogenicity PMID: 12768012
- Rab9 GTPase stability on late endosomes required interaction with TIP47 PMID: 15456905
- TIP47 and adipophilin are components of many, but not all, the lipid droplets in THP-1 cells PMID: 15545278
- we report the identity of an inhibitor, TIP47, which prevents retinylester hydrolysis catalyzed by GS2 lipase and hormone-sensitive lipase PMID: 16741517
- Binding of the effector protein TIP47 is important for Rab9 localization. PMID: 16769818
- The results suggested that the putative hydrophobic cleft is critical for the unique characteristics of TIP47. PMID: 16808905
- These results show that TIP47 is a cellular cofactor that plays an essential role in Env incorporation, allowing the encounter and the physical association between HIV-1 Gag and Env proteins during the viral assembly process. PMID: 17003132
- Adipophilin and TIP47 are expressed in LDs of vitamin A-storing hepatic stellate cells and additionally in lipid droplets of steatotic hepatocytes. PMID: 18393390
- The present results suggest that lipid droplets (LD) and LD-associated proteins have protective effects against apoptosis induced by fatty acid-bound albumin by sequestering free fatty acids. PMID: 18832575
- TIP47 (tail-interacting protein 47 kD) protein levels directly correlate with triglyceride levels; TIP47 may act as a carrier protein for free fatty acids and in this way participates in conversion of macrophages into foam cells PMID: 19286631
- VV p37 protein associates with host TIP47, Rab9 and CI-MPR. PMID: 19400954
- TIP47 has apolipoprotein-like properties and reorganizes liposomes into small lipid discs PMID: 19451273
顯示更多
收起更多
-
亞細胞定位:Cytoplasm. Endosome membrane; Peripheral membrane protein; Cytoplasmic side. Lipid droplet.
-
蛋白家族:Perilipin family
-
數據庫鏈接:
Most popular with customers
-
-
YWHAB Recombinant Monoclonal Antibody
Applications: ELISA, WB, IHC, IF, FC
Species Reactivity: Human, Mouse, Rat
-
Phospho-YAP1 (S127) Recombinant Monoclonal Antibody
Applications: ELISA, WB, IHC
Species Reactivity: Human
-
-
-
-
-